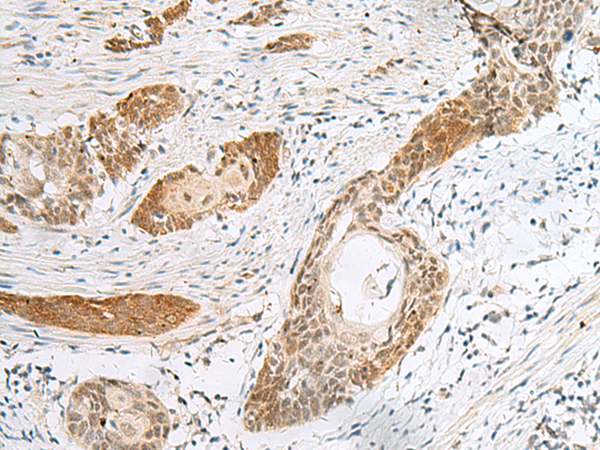

中文名稱:兔抗H2BC12多克隆抗體
英文名稱: Anti-H2BC12 rabbit polyclonal antibody
別 名: H2B clustered histone 12; H2BK; H2B/S; H2BFT; H2BF
儲 存: 冷凍(-20℃)
抗 原: H2BC12
宿 主: Rabbit
相關(guān)類別: 一抗
反應(yīng)種屬: Human, Mouse
標(biāo)記物: Unconjugate
克隆類型: rabbit polyclonal
Background:
Histones are basic nuclear proteins that are responsible for the nucleosome structure of the chromosomal fiber in eukaryotes. Two molecules of each of the four core histones (H2A, H2B, H3, and H4) form an octamer, around which approximately 146 bp of DNA is wrapped in repeating units, called nucleosomes. The linker histone, H1, interacts with linker DNA between nucleosomes and functions in the compaction of chromatin into higher order structures. This gene encodes a replication-dependent histone that is a member of the histone H2B family. The protein encoded is an antimicrobial protein with antibacterial and antifungal activity. Two transcripts that encode the same protein have been identified for this gene, which is found in the histone microcluster on chromosome 6p21.33. [provided by RefSeq, Aug 2015]
Applications:
ELISA, IHC
Name of antibody:
H2BC12
Immunogen:
Fusion protein of human H2BC12
Full name:
H2B clustered histone 12
Synonyms:
H2BK; H2B/S; H2BFT; H2BFAiii; HIST1H2BK
SwissProt:
O60814
IHC positive control:
Human esophagus cancer
IHC Recommend dilution:
30-150
技術(shù)規(guī)格
購物車
幫助
021-54845833/15800441009
